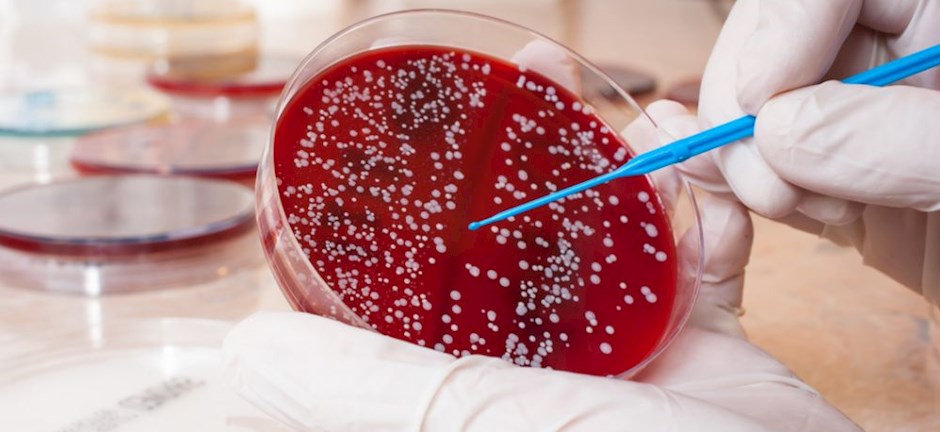
stafylokokos

Σταφυλόκοκκος στο ουροποιητικό
Η λοίμωξη του ουροποιητικού συστήματος από σταφυλόκοκκο — ιδιαίτερα από το είδος Staphylococcus aureus — αποτελεί σχετικά σπάνια αλλά σημαντική κλινική οντότητα. Στις περισσότερες περιπτώσεις ουρολοιμώξεων πρωταγωνιστούν άλλα βακτήρια (όπως Ε. coli), ωστόσο ο σταφυλόκοκκος μπορεί να εμφανιστεί — συχνά σε ειδικές πληθυσμιακές ομάδες ή υπό συνθήκες όπως ύπαρξη καθετήρα.
Σε αυτό το άρθρο θα αναλύσουμε τι σημαίνει «σταφυλόκοκκος στα ούρα», ποιοι είναι οι παράγοντες κινδύνου, τα συμπτώματα, η διάγνωση, η θεραπεία, η πρόληψη και οι πιθανές επιπλοκές.
Τι είναι η λοίμωξη από σταφυλόκοκκο στο ουροποιητικό
Το βακτήριο Staphylococcus aureus (και σπανιότερα άλλα είδη του γένους Staphylococcus) μπορεί να εντοπιστεί σε δείγματα ούρων.
Αν και η παρουσία του στα ούρα μπορεί να αντιπροσωπεύει απλώς αποικισμό ή ακόμη και μόλυνση δείγματος, σε ορισμένες περιπτώσεις μπορεί να σημαίνει ενεργή λοίμωξη του ουροποιητικού (ουρολοίμωξη) ή και δευτερογενή σήψη.
Η λοίμωξη συμβαίνει πιο συχνά σε ασθενείς με καθετήρα, νοσοκομειακή περίθαλψη, ανοσοκαταστολή ή άλλους σχετικούς παράγοντες κινδύνου.
Αιτίες & παράγοντες κινδύνου
Αιτίες
Εισβολή του βακτηρίου στο ουροποιητικό, για παράδειγμα μέσω καθετήρα (ουροκαθετηριασμός) ή χειρουργικής επέμβασης.
Μετάδοση από άλλες εστίες στο σώμα (π.χ. αιματογενής διασπορά) — ειδικά όταν υπάρχει βακτηριαιμία από σταφυλόκοκκο και ανιχνεύεται στα ούρα.
Ανοσοκαταστολή, χρόνιες παθήσεις, υπερήλικες, χρήση εμφυτευμένων συσκευών (όπως ουροκαθετήρας) που διευκολύνουν την αποικισμό ή λοίμωξη.
Παράγοντες κινδύνου
Χρήση καθετήρα ούρων για μεγάλο διάστημα.
Νοσηλεία σε νοσοκομείο ή μονάδα εντατικής θεραπείας.
Προϋπάρχουσες ουρολογικές παθήσεις ή χειρουργική επέμβαση.
Σύνδρομα ανοσοκαταστολής (π.χ. διαβήτης, HIV/AIDS).
Προηγούμενη λοίμωξη από σταφυλόκοκκο ή ύπαρξη MRSA (ανθεκτικών στελεχών).
Συμπτώματα
Η παρουσία σταφυλόκοκκου στα ούρα μπορεί να εκδηλωθεί όπως οποιαδήποτε ουρολοίμωξη — αλλά ενδέχεται να είναι πιο επιπλεγμένη.
Κάποια από τα συνήθη συμπτώματα είναι:
Συχνουρία, επιτακτική ανάγκη ούρησης, καύσος κατά την ούρηση.
Πόνος ή βάρος στο κατώτερο μέρος της κοιλιάς (κυστική μορφή).
Πυρετός, ρίγη — ειδικά αν η λοίμωξη εξελιχθεί προς το άνω ουροποιητικό ή αίμα.
Αν υπάρχει καθετήρας: αύξηση θολότητας των ούρων, αίμα στα ούρα, κακοσμία.
Επειδή σταχυλόκοκκος μπορεί να αποτελεί ένδειξη πιο βαριάς λοίμωξης (π.χ. βακτηριαιμίας), η παρουσία του στα ούρα χρήζει προσοχής.
Διάγνωση
Η διάγνωση μιας λοίμωξης από σταφυλόκοκκο στο ουροποιητικό περιλαμβάνει:
Καλλιέργεια ούρων με ποσοτική μέτρηση (CFU/ml) και ταυτοποίηση του βακτηρίου.
Αντιβιόγραμμα (δοκιμή ευαισθησίας) διότι συχνά τα στελέχη μπορεί να είναι ανθεκτικά (π.χ. MRSA).
Εξέταση για παρουσία καθετήρα, ουρολογικών ανατομικών ανωμαλιών ή άλλων προδιαθεσικών καταστάσεων.
Σε περιπτώσεις όπου υπάρχει αίμα στα ούρα ή βακτηριαιμία, ενδεχομένως επιπλέον εξετάσεις (π.χ. υπερηχογράφημα νεφρών, επιπλοκές).
Θεραπεία
Η θεραπεία εξαρτάται από τη σοβαρότητα της λοίμωξης, την ύπαρξη παράγοντα κινδύνου, και το αν το στέλεχος είναι ανθεκτικό.
Σε απλές περιπτώσεις: κατάλληλη αντιβίωση που καθορίζεται με βάση τα αποτελέσματα του αντιβιογράμματος.
Σε περίπτωση καθετήρα: αφαίρεση ή αντικατάσταση του καθετήρα μπορεί να είναι απαραίτητη.
Σε πιο επίμονες/σοβαρές λοιμώξεις (π.χ. με βακτηριαιμία): ενδοφλέβια αντιβίωση, νοσηλεία.
Παρακολούθηση της ανταπόκρισης στη θεραπεία και πιθανής επανεξέτασης της καλλιέργειας για να βεβαιωθεί ότι η μόλυνση εξαλείφθηκε.
Πρόληψη
Για την πρόληψη των ουρολοιμώξεων από σταφυλόκοκκο, προτείνονται τα εξής:
Περιορισμός (όσο είναι δυνατόν) της χρήσης καθετήρων και προσεκτική διαχείρισή τους με καλή υγιεινή.
Καλή υγιεινή του ουροποιητικού συστήματος, π.χ. τακτική κένωση της ουροδόχου κύστης.
Προσοχή σε νοσοκομειακό περιβάλλον: χρήση προφυλάξεων (όπως απομόνωση αν υπάρχει MRSA).
Έγκαιρη διάγνωση και θεραπεία λοίμωξης για να αποτραπεί επέκταση σε πιο βαριά μορφή.
Επιπλοκές
Η λοίμωξη από σταφυλόκοκκο στο ουροποιητικό μπορεί να οδηγήσει σε:
Ανάπτυξη βακτηριαιμίας (διάδοση του βακτηρίου στο αίμα) — ιδιαίτερα σε υψηλού κινδύνου ασθενείς.
Ανιούσα λοίμωξη προς τους νεφρούς (πυελονεφρίτιδα) ή σχηματισμός αποστημάτων.
Καταστάσεις που σχετίζονται με καθετήρα: σχηματισμός βιοφίλμ, επιμονή μόλυνσης.
Ανθεκτικά στελέχη (π.χ. MRSA) που καθιστούν τη θεραπεία δυσκολότερη.
Συμπέρασμα
Η ανίχνευση σταφυλόκοκκου στα ούρα — ειδικά του είδους Staphylococcus aureus — δεν πρέπει να θεωρείται απαραίτητα απλή «μόλυνση δείγματος». Ιδιαίτερα όταν υπάρχουν παράγοντες κινδύνου (καθετήρας, ασθενής νοσοκομείου, ανοσοκαταστολή), απαιτείται ολοκληρωμένη αξιολόγηση. Η έγκαιρη διάγνωση, η κατάλληλη θεραπεία και η λήψη μέτρων πρόληψης μπορούν να αποτρέψουν σοβαρές επιπλοκές.
Αν υποπτεύεστε λοίμωξη στο ουροποιητικό σύστημα ή έχετε αποτελέσματα καλλιέργειας με σταφυλόκοκκο, συστήνεται η επικοινωνία με ουρολόγο ή μικροβιολόγο για τη σωστή διαχείριση.